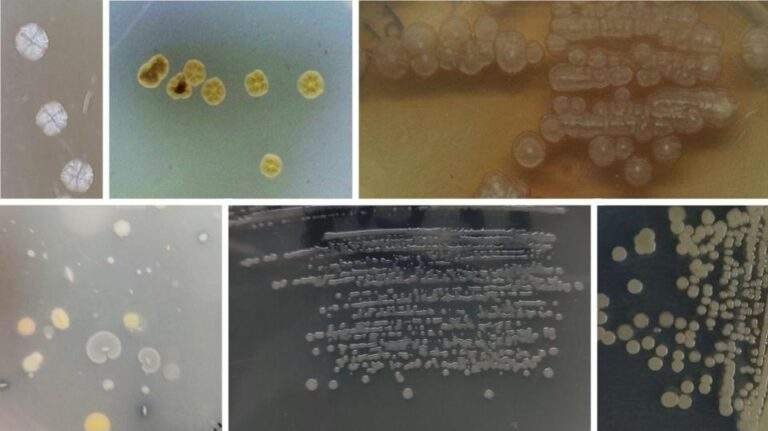

India with around 49,000 plant species so far known –...
Read MoreCONNECTING PEOPLE FOR SUSTAINABLE TOMORROW











Join us in revolutionizing agriculture through eco-friendly practices and organic solutions. Together, we empower communities and build a sustainable future for farmers and nature
Our Unique Approach to Sustainability
Regenerating Land, Sustaining Lives and Protecting Biodiversity
Integrated Community-Based Programs
Rural Health Research
Industrial Development
Climate Change Mitigation and Adaptation Strategies
Transforming Waste into Resources to Drive Sustainability and Economic Growth
Disaster Risk Reduction
Scientific and Industrial Research


OUR STORY
The Eco Tribe Journey
Eco Tribe Foundation has pioneered an approach that melds indigenous knowledge systems with cutting-edge technology to develop enduring solutions for complex environmental and social challenges. Working directly with farmers and tribal populations, the Foundation fosters biodiversity protection, enhances crop productivity, and develops stable food networks while respecting cultural traditions. Our multidimensional framework addresses biodiversity preservation, regenerative farming practices, water resource stewardship, waste valorization processes, climate adaptation strategies, and economically sustainable livelihood opportunities. Underpinning these efforts in scientific and industrial research based on lab to land approach and community-based crisis, which validates traditional practices, optimizes technological applications, and ensures the scalability and long-term effectiveness of the Foundation’s interventions.
The Foundation’s operational framework is grounded in principles of environmental sustainability, community self-reliance, and social inclusion, enabling it to serve as a catalyst for balanced development across various sectors. These include indigenous wisdom preservation, women’s economic empowerment, disaster readiness, alternative energy adoption, healthcare access, educational enrichment, and integrated farming systems. Through this coordinated, systems-based approach, the Eco Tribe Foundation is creating durable positive outcomes by supporting communities that flourish in harmony with their natural surroundings, thoughtfully blending time-honored practices with appropriate contemporary innovations, and comprehensively addressing all 17 Sustainable Development Goals through its holistic and integrated initiatives.
Our Fundamental Goals Towards a Sustainable Future
We are committed to promote ecosystem balance, community resilience initiatives, and sustainable development through the following key initiatives
1. Biodiversity Conservation



2. Sustainable Rural and Urban Livelihoods





3. Regenerative and Chemical-Free, Sustainable Agriculture Practices





4. Food and Nutrition




5. Health and Family Welfare



6. Education and Literacy



7. Scientific and Industrial Research for Socio Economic Development


8. Climate-resilient Socio-economic Practices






9. "Waste to Wealth" Initiatives






10. Animal Welfare, Livestock Management, and Aquaculture





11. Women Empowerment





12. Anthropological Conservation




13. Government Linkage



14. Composite Farming Practice



15. Integrate traditional knowledge systems with modern science


Loading weather data...
Recent
Highlights
Empowering Tribal Farmers with Indigenous Seeds: A Step
At Eco Tribe Foundation, our mission is rooted in the...
Read MoreEmpowering Communities: How Eco Tribe Foundation (ETF) will
India’s healthcare system is changing quickly, and ETF will be...
Read MoreHarnessing the Power of Agro Beneficial Microflora: A
The world’s growing population demands increased food production, but conventional...
Read MoreA Day with Young Dreamers: Growing Mushrooms, Growing
Growing Mushrooms, Growing Hope: A Day with Young Dreamers 19.12.2024,...
Read MoreA Seed of Hope Sprouts in Mahammad Bazar
Fullaipur, a village, located in the heart of Birbhum district...
Read More
A Seed of Hope Sprouts in Mahammad Bazar Block, Birbhum
A heartwarming story of how sustainable farming practices are reviving hope and livelihoods in the village of Fullaipur.

Our Laboratory for Community Health Research
Eco Tribe Foundation empowers communities through participatory research, enhancing healthcare access and creating …

A Day with Young Dreamers: Growing Mushrooms, Growing Hope
Blending traditional wisdom with modern methods, we provide hands-on training to enhance efficiency, resilience …

Jeevamrut: Ancient Wisdom Reviving Soil Health and Boosting Plant Vitality
In the quest for sustainable farming practices, ancient wisdom often provides the most effective solutions. Jeevamrut, a traditional organic fertilizer rooted in Indian agricultural practices, has emerged as…

When COVID-19 swept through our communities, it brought fear, uncertainty, and tremendous hardship. But it also revealed the strength of unity, the power of compassion, and the critical role grassroot …
Harnessing the Power of Agro Beneficial Microflora: A Sustainable Future for Agriculture
The world’s growing population demands increased food production, but conventional agricultural practices relying heavily on synthetic fertilizer …